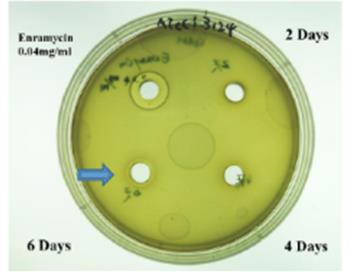

地衣芽孢桿菌固態發酵條件最適化及對梭菌攻毒雞隻之保護效果發佈日期:2018/02/01
實施期間起迄
107年02月01日執行單位
游玉祥助理教授 / 國立宜蘭大學執行成果
家禽產業在育種篩選與基因改良技術下,已大幅改善肉雞之生長速率及飼料換肉率,但肉雞快速生長卻容易引起骨骼生長不良、代謝異常或病原菌感染,家禽壞死性腸炎(necrotic enteritis, NE)為肉雞在全球家禽商業化飼養中常見之疾病,容易導致肉雞的死亡,進而影響雞農的經濟效益損失,家禽壞死性腸炎的主要致病菌為產氣莢膜梭菌(Clostridium perfringens)。早期商業飼養常會於飼料中添加抗生素以預防家畜禽腸道疾病發生,抗生素的添加也能改善畜禽的生長性能,但歐盟自2006年已全面禁止抗生素添加,國際間也逐漸減少抗生素使用,近年來由於消費者關注無藥物殘留及安全食品的訴求,因此抗生素的禁用漸被重視。因此其替代品之研發相對受重視。經分析健康動物之腸道菌相,發現有些微生物長期定殖於腸道中,又稱為益生菌(probiotics),經動物攝食後,利用此外源菌種之特性使其成為腸道內之優勢菌種,藉以調整腸道內之菌相,降低病源菌之增殖,因此能改善動物之腸道健康,達到降低使用抗生素之機會。益生菌已經廣為在畜禽產業應用以作為動物飼料之抗生素替代品,其中芽孢桿菌屬(Bacillus spp.)是常被使用之益生菌,特別是枯草桿菌(Bacillus subtilis)。地衣芽孢桿菌(Bacillus licheniformis)為新穎的芽孢桿菌,地衣芽孢桿菌用於動物飼料或做為抗生素替代品之研究相當稀少,因此本研究目的為探討地衣芽孢桿菌之固態發酵條件、菌株穩定性及抗菌特性。試驗結果顯示地衣芽孢桿菌於固態發酵的最佳條件培養基質為5%葡萄糖、10%大豆粕及3%酵母粉,於50%之初始水分含量進行4日或6日發酵可達最佳菌數,發酵4日和6日的產物中之孢子具有最佳的耐熱和耐酸之能力,更進一步證實6日的產物對產氣莢膜梭菌具有最佳的抗菌活性。綜合上述,所建立的固態發酵條件及抗菌活性將可用於未來探討地衣芽孢桿菌是否能減緩產氣莢膜梭菌所導致的家禽壞死性腸炎,以評估地衣芽孢桿菌作為抗生素替代品之潛力。